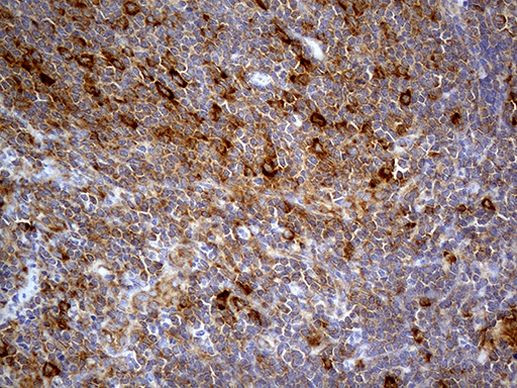
ABCF2 Antibody in Immunohistochemistry (Paraffin) (IHC (P))

Search
OriGene
ABCF2 Monoclonal Antibody (OTI8F4), TrueMAB™
{{$productOrderCtrl.translations['antibody.pdp.commerceCard.promotion.promotions']}}
{{$productOrderCtrl.translations['antibody.pdp.commerceCard.promotion.viewpromo']}}
{{$productOrderCtrl.translations['antibody.pdp.commerceCard.promotion.promocode']}}: {{promo.promoCode}} {{promo.promoTitle}} {{promo.promoDescription}}. {{$productOrderCtrl.translations['antibody.pdp.commerceCard.promotion.learnmore']}}
产品信息
TA811105
种属反应
宿主/亚型
分类
类型
克隆号
抗原
偶联物
形式
浓度
规格
纯化类型
保存液
内含物
保存条件
运输条件
靶标信息
OCIAD1 was identified via immunoscreening of an ovarian carcinoma cDNA library from ovarian cancer patients and is expressed in multiple tissues including ovary, placenta, brain, testis, prostate, and mammary gland. Two isoforms of OCIAD1 are known to exist; the shorter isoform is restricted to the central nervous system. OCIAD1 is a transmembrane protein whose overexpression in HEY ovarian cancer cells increased lysophosphatidic acid- (LPA-)induced, but not basal level cell adhesion to extracellular matrix proteins collagen I and laminin10/11. This adhesion is not blocked by LY294002 and GF109203X, suggesting that OCIAD1 does not use protein kinase C and PI3 kinase signaling pathways to exert its effect on adhesion.
仅用于科研。不用于诊断过程。未经明确授权不得转售。
篇参考文献 (0)
生物信息学
蛋白别名: ABC-type transport protein; abcf2; ATP-binding cassette sub-family F member 2; ATP-binding cassette, sub-family F (GCN20), member 2; developmentally regulated repeat element-containing transcript 3; DKFZp586K1823; Iron-inhibited ABC transporter 2; M-ABC1
基因别名: 0710005O05Rik; ABC28; ABCF2; Drr3; E430001O06; EST133090; HUSSY-18; HUSSY18
UniProt ID: (Human) Q9UG63, (Mouse) Q99LE6
Entrez Gene ID: (Human) 10061, (Mouse) 27407